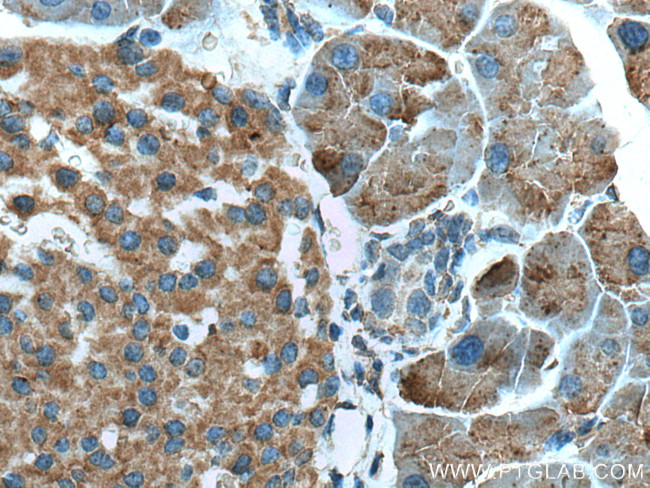
ZG16 Antibody in Immunohistochemistry (Paraffin) (IHC (P))

Search
Proteintech
ZG16 Monoclonal Antibody (1A7B9)
{{$productOrderCtrl.translations['antibody.pdp.commerceCard.promotion.promotions']}}
{{$productOrderCtrl.translations['antibody.pdp.commerceCard.promotion.viewpromo']}}
{{$productOrderCtrl.translations['antibody.pdp.commerceCard.promotion.promocode']}}: {{promo.promoCode}} {{promo.promoTitle}} {{promo.promoDescription}}. {{$productOrderCtrl.translations['antibody.pdp.commerceCard.promotion.learnmore']}}
产品信息
67389-1-IG
种属反应
宿主/亚型
分类
类型
克隆号
抗原
偶联物
形式
浓度
规格
纯化类型
保存液
内含物
保存条件
运输条件
产品详细信息
Aliquoting is unnecessary for -20°C storage.
仅用于科研。不用于诊断过程。未经明确授权不得转售。
生物信息学
蛋白别名: jacalin-like lectin domain containing; Secretory lectin ZG16; unnamed protein product; Zymogen granule membrane protein 16; Zymogen granule protein 16; zymogen granule protein 16 homolog
基因别名: 1810010M01Rik; AI593689; JCLN; JCLN1; Zg-16p; ZG16; ZG16A; ZG16p
UniProt ID: (Human) O60844, (Mouse) Q8K0C5, (Rat) Q8CJD3
Entrez Gene ID: (Pig) 100620560, (Human) 653808, (Mouse) 69036, (Rat) 171449